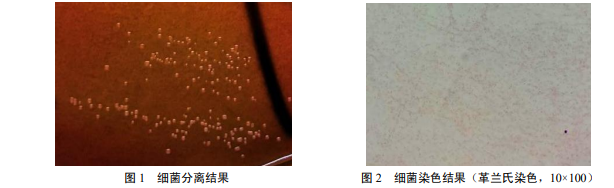

多殺性巴氏桿菌(Pasteurella multocida)是引起畜禽巴氏桿菌病的病原菌,是一種革蘭氏陰性短 桿菌,有莢膜,無鞭毛、不形成芽胞、不運動,可感染家禽、豬和牛等多種動物以及人,引起禽霍亂、豬肺疫和牛出血性敗血癥等多種傳染病。多殺性巴氏桿菌病廣泛流行于世界各地,目前在我國多種 家畜、家禽和野生動物中均有多殺性巴氏桿菌病發生,且發病率和死亡率均較高,給畜禽生產帶來巨 大的經濟損失,是危害畜禽養殖業的重要細菌傳染病之一。因此,畜禽多殺性巴氏桿菌病的診斷和 防治至關重要。
1 試驗材料
1.1 病料來源
江西省南昌市某雞場送檢發病烏雞的肝臟等病料。
1.2 主要試劑和儀器
普通瓊脂培養基、鮮血瓊脂培養基和 TSA 培養基,由實驗室自制;小牛血清, 購自杭州江濱生物技術有限公司;PCR Mix、100 bp DNA Ladder,購自北京全式金生物科技有限公司; 膠回收試劑盒,購自 Omega 公司;飽和酚、溴化乙錠(EB)、SDS、Tris 堿等,購自 Solarbio 公司;瓊 脂糖購自 Sigma 公司;藥敏紙片,購自杭州微生物試劑有限公司。
1.3 主要儀器
SW-CJ 型凈化工作臺,購自蘇州凈化設備有限公司;YXQ-LS-75S11 型立式壓力蒸氣滅菌器、 SPX-150B-Z 型生化培養箱,購自上海博訊實業有限公司醫療設備廠;5415R 型冷凍臺式高速離心機,購 自 Eppendorf 公司;K960 型 PCR 儀,購自杭州晶格儀器有限公司。
1.4 引物設計
分離株的 16S rRNA 基因序列的擴增采用細菌 16S rRNA 通用引物,引物由上海生工生物工程股份有 限公司合成。引物序列如下: 16S(F)5'-AGAGTTTGATCCTGGCTCAG-3',16S(R)5'-GGTTACCTTG TTACGACTT-3'。
2 試驗方法
2.1 細菌分離
無菌取發病雞肝臟,分別接種于鮮血瓊脂培養基和普通瓊脂培養基,在 37 ℃恒溫箱中培養 24 h 后 進行觀察,挑取可疑單個菌落進行純化培養。
2.2 染色鏡檢
勾取純化培養的單個菌落進行革蘭氏染色,油鏡鏡檢,觀察記錄其形態特征。
2.3 細菌
16S rDNA 鑒定
2.3.1 細菌
DNA 提取 取一支 1.5 mL EP 管,加入 100 μL 雙蒸水,勾取 2 接種環純化培養的單個菌落, 混勻,煮沸 10~15 min;12 000 r/min 離心 7 min,取上清,作為細菌 DNA 模板,-20 ℃保存備用。
2.3.2 細菌
16S rDNA 的 PCR 擴增 PCR 反應體系:總體積為 25 μL,其中含 16S (F)和 16S (R)各 1 μL、 PCR Mix 12.5 μL、DNA 模板 1 μL 以及 ddH2O 9.5 μL。PCR 反應程序:94 ℃預變性 5 min;94 ℃變性 40 s, 55 ℃退火 50 s,72 ℃延伸 50 s,34 個循環;72 ℃延伸 10 min。PCR 反應產物用 10 g/L 瓊脂糖凝膠進行 電泳,30 min 后在紫外燈下觀察結果,并拍照記錄。
2.3.3 16S rDNA 測序與序列分析
用膠回收試劑盒回收目的片段,將純化回收的目的片段送至上海華大基因生物科技有限公司雙向測通測序。運用 NCBI 基因庫中的 BLAST 對獲得的序列進行同源性檢索, 與細菌 16S rRNA 基因序列進行對比,若同源性百分比≥99%,可以定義到種的水平;若同源性在 97%~98.9%,可以定義到屬的水平;若<97%,則定義為科。選取與分離菌 16S rDNA 基因序列同源性 高的細菌用 DNAStar 進行核苷酸同源性比對分析。
2.4 藥敏實驗
采用藥敏紙片擴散法,取 100 μL 小牛血清涂布于 TSA 培養基,于 37 ℃恒溫箱放置 5 min,干燥后 將藥敏紙片貼于 TSA 培養基上,置于 37 ℃恒溫箱中培養 24 h 后測量抑菌圈直徑。判定標準:抑菌圈直 徑<10 mm 為耐藥;抑菌圈直徑在 10~15 mm 為中度敏感;抑菌圈直徑>15 mm 為高敏。
3 結果與分析
3.1 細菌分離結果
分離菌在鮮血瓊脂培養基上形成圓形、邊緣規則、表面光滑、乳白色的露滴狀小菌落,無溶血現象 (圖 1);在普通瓊脂培養基上幾乎不生長。
3.2 染色鏡檢
分離菌經革蘭氏染色后進行鏡檢,結果如圖 2。可見分離株為革蘭氏陰性的短桿菌,菌體兩端鈍圓, 呈單個散在分布或成雙存在。可疑為多殺性巴氏桿菌,并命名為 JX-Pm01。
3.3 細菌
16S rDNA 鑒定
3.3.1 16S rDNA 基因 PCR 擴增結果
如圖 3 所示,可以看到 1 條清晰的條帶,且長度約為 1 500 bp, 與預期大小相符。
3.3.2 16S rDNA 基因測序與序列分析
分離株 JX-Pm01 的基 因片段長度為 1 443 bp,所得序列與 NCBI 基因庫 BLAST 中多 殺性巴氏桿菌 16S rDNA 基因序列同源性達 100%,初步判定該 分離菌株為多殺性巴氏桿菌。選取 BLAST 同源性檢索中與分離 菌同源性較高的多殺性巴氏桿菌殺禽亞種(Pasteurella multocida subsp. gallicida)、多殺性巴氏桿菌敗血亞種(Pasteurella multocida subsp. septica)、咬傷巴氏桿菌(Pasteurella dagmatis)、 犬巴氏桿菌(Pasteurella canis)、咽巴氏桿菌(Pasteurella stomatis)、 口巴氏桿菌(Pasteurella oralis)、買氏巴氏桿菌(Pasteurella mairii)、產氣巴氏桿菌(Pasteurella aerogenes)、豚放線桿菌 ( Actinobacillus porcinus )、流感嗜血桿菌( Haemophilusinfluenzae)、副豬嗜血桿菌(Haemophilus parasuis)、多源曼氏桿菌(Mannheimia varigena)、溶血性曼 氏桿菌(Mannheimia haemolytica)與分離菌 JX-Pm01 的 16S rDNA 基因序列進行同源性比對分析,結果如 圖 4。 結果表明JX-Pm01 與巴氏桿菌核苷酸相似性達 91.3%~99.3%,與多殺性巴氏桿菌同源性達99.1%, 其中多殺性巴氏桿菌殺禽亞種與 JX-Pm01 同源性最高,達 99.3%,進一步表明分離株為多殺性巴氏桿 菌殺禽亞種。而與同科的豚放線桿菌、流感嗜血桿菌、副豬嗜血桿菌、多源曼氏桿菌、溶血性曼氏桿 菌核苷酸同源性高達 91.4%~97.3%,說明巴氏桿菌各種屬之間的差異性較小,尤其與咽巴氏桿菌的同 源性達 97.3%。


4 小結與討論
試驗從患病雞肝臟分離到一株細菌 JX-Pm01,經染色鏡檢結合臨床癥狀和病理剖檢,可疑為多殺性 巴氏桿菌。經 16S rDNA 基因片段 PCR 擴增與測序分析,基本判定其為多殺性巴氏桿菌殺禽亞種。 多殺性巴氏桿菌引起的禽霍亂被 OIE 列為 B 類疫病,其發病率和死亡率均較高。及時準確診斷對 于該病的防治,降低養殖戶的損失有重要意義。選用抗菌藥物仍是防治霍亂的主要措施,然而耐藥性的 產生,甚至是多藥耐藥基因,使本病的藥物治療效果不佳。本試驗通過藥敏試驗,結果表明 JX-Pm01 對氨芐西林、丁胺卡那、多西環素和恩諾沙星敏感,對頭孢哌酮、四環素、環丙沙星和復方新諾明中度 敏感,而對頭孢曲松、卡那霉素、氟苯尼考、紅霉素、林可霉素和諾氟沙星耐藥。這與邊彥超等和王 彩麗等報道的多殺性巴氏桿菌對藥物的敏感與本試驗分離菌的耐藥性存在不少差異。因此當養殖場發 生多殺性巴氏桿菌病時,需要根據藥敏試驗篩選藥物進行科學用藥,減少病原菌對抗生素耐藥性的產生, 使其獲得良好的治療效果。